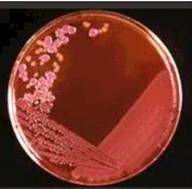
痢疾桿菌

性狀
大小為0.5-0.7×2-3μm,無芽胞,無莢膜,無鞭毛。多數有菌毛。 痢疾桿菌
痢疾桿菌(1)A群:又稱痢疾志賀氏菌(Sh.dysenteriae),通稱志賀氏痢疾桿菌。不發酵甘露醇。有12個血清型,其中8型又分為三個亞型。
(2)B群:又稱福氏志賀氏菌(Sh.flexneri),通稱福氏痢疾桿菌。發酵甘露醇。有15個血清型(含亞型及變種),抗原構造複雜,有群抗原和型抗原。根據型抗原的不同,分為6型,又根據群抗原的不同將型分為亞型;X、Y變種沒有特異性抗原,僅有不同的群抗原。
(3)C群:又稱鮑氏志賀氏菌(Sh.boydii),通稱鮑氏痢疾桿菌。發酵甘露醇,有18個血清型,各型間無交叉反應。
(4)D群:又稱宋內氏志賀氏菌(Sh.sonnei),通稱宋內氏痢疾桿菌。發酵甘露醇,並遲緩發酵乳糖,一般需要3-4天。只有一個血清型。有兩個變異相,即Ⅰ相和Ⅱ相;Ⅰ相為S型,Ⅱ相為R型。
痢疾桿菌
痢疾桿菌根據志賀氏菌的菌型分布調查,中國一些主要城市在過去二、三十年中均以福氏菌為主,其中以又2a亞型、3型多見;其次為宋內氏菌;志賀氏菌與鮑氏菌則較少見。志賀氏菌Ⅰ型的細菌性痢疾已發展為世界性流行趨勢,中國至少在10個省、區發生了不同規模流行。了解菌群分布與菌型變遷情況,對製備菌苗,預防菌痢具有重大意義。
本菌對理化因素的抵抗力較其他腸道桿菌為弱。對酸敏感,在外界環境中的抵抗力能以宋內氏菌最強,福氏菌次之,志賀氏菌最弱。一般56-60℃經10分鐘即被殺死。在37℃水中存活20天,在冰塊中存活96天,蠅腸內可存活9-10天,對化學消毒劑敏感,1%石碳酸15-30分鐘死亡。
1.S-R型變異:宋內氏痢疾桿菌易為R型。當菌落變異時,常伴有生化反應、抗原構造和致病性的改變。
2.耐藥性變異:由於廣泛使抗生素,志賀氏菌的耐藥菌株不斷增加,給防治工作帶來多困難。
3.營養缺陷型變異:南斯拉夫Mel(1963年)首創的依賴鏈黴素的志賀氏菌株(依鏈株,Sd),作為口服菌苗可預防志賀氏菌痢疾。
致病性
1.侵襲力:侵襲力:菌毛是侵襲力的基礎,是痢疾桿菌致病的主要因素之一。 痢疾桿菌生活史
痢疾桿菌生活史2.內毒素:各型痢疾桿菌都具有強烈的內毒素。內毒素作用於腸壁,使其通透性增高,促進內毒素吸收,引起發熱,神志障礙,甚至中毒性休克等。內毒素能破壞黏膜,形成炎症、潰湯,出現典型的膿血粘液便。內毒素還作用於腸壁植物神經系統,至腸功能紊亂、腸蠕動失調和氫攣,尤其直腸括約肌痙攣最為明顯,出現腹痛、里急後重(頻繁便意)等症狀。
3.外毒素:志賀氏菌A群Ⅰ型及部分2型菌株還可產生外毒素,稱志賀氏毒素。為蛋白質,不耐熱,75-80℃1小時被破壞。該毒素具有三種生物活性:①神經毒性,將毒素注射家兔或小鼠,作用於中樞神經系統,引起四肢麻痹、死亡;②細胞毒性,對人肝細胞、猴腎細胞和HeLa細胞均有毒性;③腸毒性,具有類似大腸桿菌、霍亂弧菌腸毒素的活性,可以解釋疾病早期出現的水樣腹瀉。
細菌性痢疾是最常見的腸道傳染病,夏秋兩季患者最多。傳染源主要為病人和帶菌者,通過污染了痢疾桿菌的食物、飲水等經口感染。人類對志賀氏菌易感,10-200個細菌可使100-50%志願者致病。一般說來,志賀氏菌所致菌痢的病情較重;宋內氏菌引起的症狀較輕;福氏菌介於二者之間,但排菌時間長,易轉為慢性。
1.急性細菌性痢疾:分為典型菌痢、非典型菌痢和中毒性菌痢三型。中毒性菌痢多見於小兒,各型痢疾桿菌都可引起。發病急,常在腹痛、腹瀉未出現,呈現嚴重的全身中毒症狀。
2.慢性細菌性痢疾:急性菌痢治療不徹底,或機體抵抗力低、營養不良或伴有其他慢性病時,易轉為慢性。病程多在二個月以上,遷延不愈或時愈時發。
部分患者可成為帶菌者,帶菌者不能從事飲食業、炊事及保育工作。
免疫性
病後免疫力不牢固,不能防止再感染。但同一流行期中再感染者較少,即具有型特異性免疫。痢疾桿菌菌型多,各型間無交叉免疫。機體對菌痢的免疫主要依靠腸道的局部免疫,即腸道黏膜細胞吞噬能力的增強和SlgA的作用。SlgA可阻止痢疾桿菌粘附到腸黏膜上皮細胞表面,病後三天左右即出現,但維持時間短,由於痢疾桿菌不侵入血液,故血清型抗體(lgM、lgG)不能發揮作用。實驗診斷
在用藥前取糞便的膿血或粘液部分,標本不能混有尿液。如不能及時送檢, 痢疾桿菌
痢疾桿菌接種腸道桿菌選擇性培養基,37℃孵育18-24小時,挑取無色半透明的可疑菌落,作生化反應和血清學凝集試驗,確定菌群和菌型。如遇非典型菌株,須作系統生化反應以確定菌屬;必要時,用適量菌液接種於豚鼠結膜上,觀察24小時,如有炎症,則為有毒菌株。
1.螢光菌球法:適於檢查急性菌痢的糞便標本。將標本接種於含有螢光素標記的志賀氏菌免疫血清液體培養基中,37℃培養4-8小時。如標本中有相應型別的痢疾桿菌,繁殖後與螢光素抗體凝集成小菌球,在低倍或高倍螢光顯微鏡下易於檢出。方法簡便、快速,有一定的特異性。
2.協同凝集試驗:用志賀氏菌的lgG抗體與富含A蛋白的葡萄球菌結合,以此為試劑,測定患者糞便濾液中志賀氏菌的可溶性抗原。
